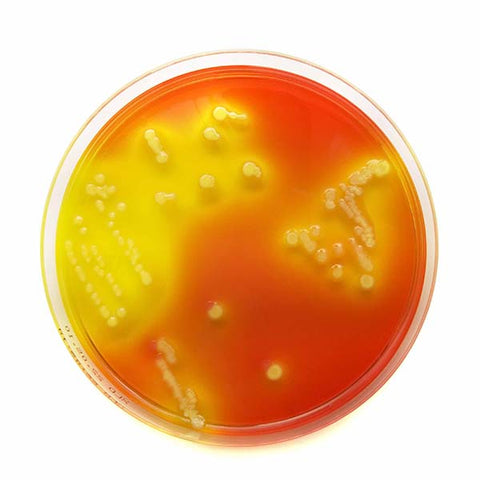
Bacteria in a petri dish

There are many different forms of life active within a compost heap. Below is a quick overview of who is living in your compost heap and what they are doing.
The Role of Bacteria and Other Micro-Organisms
Without micro-organisms, especially bacteria, there is no significant amount of composting. Spores and bacteria are everywhere - in the air, on food, on plants. Given the right conditions, the population will rapidly increase. Different bacteria and insects populate the heap according to temperature ranges and nature of contents. They grow; die and regrow depending on the conditions.
How Many Bacteria Are There?
Even a few grams of compost is estimated to contain up to a billion bacteria cells. No one really knows how many different types there are and only a tiny fraction has been classified. It is currently estimated that the total number of species of bacteria range from about 10 million to a billion (Wisegeek). Just for comparison the number of scientifically recognized species of animals is about 1,250,000 and there are almost 300,000 recognized species of plants.
The Chemical Decomposers
Micro-organisms such as bacteria, fungi, and actinomycetes account for most of the decomposition that takes place within the HOTBIN.
There are three key temperature zones within the HOTBIN; each zone houses its own type of bacteria. The bottom layer is the coolest layer followed by the warmer middle and finally the hotter, most active top layer.
|
Bacteria |
Active in Temperature Range (Approx.) |
Activity |
|
Psychrophilic |
10 - 21°C |
Present in the cooler bottom layer, they are active at lower temperatures and help to raise the temperature as they break down the waste. |
|
Mesophilic |
21 - 40°C |
Present in the warmer middle layer where they continue to generate heat and further raise the temperature as they break down the waste. |
|
Thermophilic |
40 - 75°C |
Present in the hot top layer. These bacteria eat readily available and easy to consume sugars the first few days after a 'feed'. When the ‘easy’ to digest food is gone, the bacteria population starts to decline, and the temperature starts to fall. The temperature cycle starts again when new waste is added. |
|
Mesophilic, cooling, lignin specialists |
20-40°C |
These bacteria are specialists in breaking down more resilient parts of the waste such as cellulose & lignin found in wood and paper products. |
Mesophilic bacteria can reproduce every 15 mins. Doubling at each reproduction (1/2/4/8/16), a population of 8 billion could be created in 13 hours.
In the same 13 hours, one actinomycetes will become two.
The Larger Physical Decomposers
Mites, centipedes, sow bugs, snails, millipedes, springtails, spiders, slugs, beetles, ants, flies, nematodes, flatworms, rotifers, and earthworms. These grind, suck, and chew materials into smaller pieces. Although not vital in the HOTBIN, if present they will be helping the decomposition process.
Worms
Although worms are not essential to the decomposition of waste in the HOTBIN, it is not uncommon to find the inside HOTBIN. Worms are good because not only do they decompose waste, but they leave mucus in the compost which is proving beneficial to soil fertility. So, if you have worms in your compost do not worry and if you have none do not worry either!
Worms and worm eggs can be present in any garden waste/soil and in any old compost from an existing heap that has been added which is how they get in.